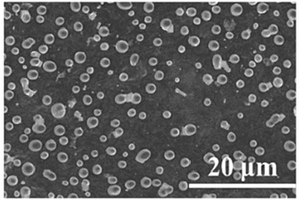

全部

 784
784
 0
0
本公开涉及一种补锂材料及其制备方法、负极和锂离子电池,该补锂材料包括金属锂颗粒和导电材料,所述导电材料包括埋入所述金属锂颗粒中的内置段和位于所述金属锂颗粒外部的外露段;所述导电材料的电子导电率大于100s/cm。本公开的补锂材料可以透过导电材料实现锂金属颗粒与负极活性材料的电子传导,增加了电子传导的通道,同时有助于锂离子的传输,实现锂离子的快速嵌入过程,使补锂效率显著提升,从而有效地抑制死锂的形成,避免形成枝晶刺穿隔膜而造成安全隐患。

 811
811
 0
0
本实用新型公开了一种磷酸铁锂电池与锂离子电容器并联模组装置,包括通过PCB连接板依次串连且并排设置的多个模组单元;模组单元包括外壳、磷酸铁锂电池和锂离子电容器;外壳为顶部开口的方形腔体结构,PCB连接板盖合在外壳上,磷酸铁锂电池和锂离子电容器并联且均安装在外壳内,磷酸铁锂电池和锂离子电容器同极的极耳穿过PCB连接板,同极穿出的极耳分别向两边翻折后焊接在PCB连接板上。本实用新型提供的并联模组装置,组合方式灵活,简单,模组兼具磷酸铁锂电池与锂离子电容器优点,在使用时可缓解模组使用过程中大电流对磷酸铁锂电池冲击,使模组装置使用寿命显著提高;同时串联过程中并联焊接点无需进行二次焊接,不良及报废率显著下降。

 1126
1126
 0
0
本发明提供一种从废旧锂电池中回收磷酸铁锂的方法。该方法包括的步骤有:获取废旧磷酸铁锂电池正极片、采用超声辅助对正极片的集流体和活性层材料分离收集和将收集的所述膏体经过洗涤、干燥、球磨处理后进行煅烧处理,获得磷酸铁锂等步骤。本发明从废旧锂电池中回收磷酸铁锂的方法采用超声辅助有机溶剂使磷酸铁锂从电池正极片上分离,直接获得磷酸铁锂材料,从而避免了大量酸碱溶剂的使用,而且避免了锂的损失,提高了回收率,能耗较低,对环境友好,不产生二次污染物。

本发明提供一种锂离子电池阴极,其包括多个纳米颗粒,该纳米颗粒是由纳米碳材及包覆在其表面的氧化物组成。制备该阴极的纳米颗粒包括如下步骤:将含所需氧化物的水溶液加入一密闭容器内,将纳米碳材加入该水溶液内,加热。本发明还提供一种锂离子电池,包括一阴极、一阳极与一渗透隔离膜,该渗透隔离膜连接阴极与阳极并将其分隔开,该锂离子电池阴极包括多个纳米颗粒,该纳米颗粒是以氧化物包覆纳米碳材而形成。

 1121
1121
 0
0
本发明涉及锂离子电池领域,公开了一种快速检测磷酸铁锂锂离子电池自放电率的方法,该方法针对目前磷酸铁锂锂离子电池由于开路电压与电池荷电状态无关,从而导致电池在使用过程中无法判断电池自放电程度的问题,提出了一种快速检测磷酸铁锂锂离子电池自放电率的方法,通过分别测量充满电状态和放完电状态并搁置一定时间后的电压值,判断该锂离子电池的自放电率,测量迅速准确,有利于大大提高生产效率和产品质量,有利于锂离子单体电池一致性的筛选,同时不需要复杂的设备和工序,可以有效降低生产成本。

 837
837
 0
0
本发明公开了一种提高锰酸锂二次锂离子电池稳定性的方法,所述方法包括将锰酸锂二次锂离子电池在50%SOC-70%SOC的充电深度条件下,或者在3.95-4.05V的储存电压条件下存储。本发明通过选用特定条件对锰酸锂二次锂离子电池进行存储,能够提高锰酸锂二次锂离子电池的稳定性、在一定程度上抑制锰酸锂电池容量衰减。

 1124
1124
 0
0
本发明公开了一种扣式锂电池的防腐处理方法及扣式锂电池,扣式锂电池的防腐处理方法包括以下步骤:S1、通过夹具将扣式锂电池进行夹持固定,所述扣式锂电池的正极端和负极端分别露出所述夹具外;S2、在所述正极端和负极端的表面分别设置导电复合涂料;S3、加热固化,所述导电复合涂料形成导电涂层。本发明通过在扣式锂电池的正极端和负极端上设置导电涂层,导体涂层同时具备优异的导电性能和防腐性能,在扣式锂电池上形成保护结构层,避免扣式锂电池的正极端和负极端被汗液、水蒸气腐蚀,并且不影响电池的装配效果。
824
824
 0
0
一种自支撑锂硫电池正极片,所述自支撑锂硫电池正极片包括碳载体、硫化锂以及过渡金属硫化物,所述硫化锂以及所述过渡金属硫化物位于所述碳载体的表面和/或所述碳载体的内部;所述硫化锂与所述过渡金属硫化物在微观结构上接触。本申请还提供一种自支撑锂硫电池正极片的制备方法,以及包括所述自支撑锂硫电池正极片的锂硫电池。

本发明提供了一种富锂锰基层状固溶体的制备方法及其制备的富锂锰基层状固溶体,其制备方法步骤包括:A、将锂源、锰源、镍源在溶剂中混合分散得均匀的混合液;B、将混合液雾化干燥,得前驱体;C、将前驱体于空气气氛下100~550℃下预烧2~15h得预烧产品;D、将步骤C所得预烧产品于空气气氛下500~1100℃下煅烧5~20h得富锂锰基层状固溶体;所述富锂锰基层状固溶体为?(1-2y)[xLi2MnO3·(1–x)LiNi0.5Mn0.5O2]·yLiNi1-xMn1+xO4,其中,0<x<1,0≤y<1;所述锂源的实际投锂量为设计分子式含锂量的50%~200%;该制备方法所用工艺具有原创性和独一性,且适合大批量工业化生产,且材料的电化学性能优异。

 1136
1136
 0
0
本发明公开一种镍钴锰酸锂高功率锂离子电池,由钢壳、 盖帽、钢壳内的正极片与负极片、隔膜、电解质溶液组成;正 极是将活性材料、导电剂和粘结剂组成的混合物均匀涂布在金 属铝箔两面而制成,负极是将活性材料、导电剂和粘结剂组成 的混合物均匀涂布在金属铜箔两面而制成,其中:所述正极涂 布混合物中活性材料镍钴锰酸锂、导电剂、粘结剂的质量百分 比分别为85~95%、1~10%、2~10%;所述负极涂布混合物 中活性材料、导电剂、粘结剂的质量百分比分别为85~97%、 0~7%、2~8%。此电池可以大电流放电,具有较低表面温 度,从而能显著提高电池的放电倍率,改善电动工具用锂离子 电池安全性能。

 792
792
 0
0
本实用新型属于锂电池技术领域,公开了一种锂电池阻燃保护壳以及高安全的锂电池,所述阻燃保护壳包括壳体和盖板;所述壳体内开设有容纳腔,且容纳腔的相邻两个侧壁为开口状;所述盖板为L型结构,且盖板密封连接于容纳腔的两个开口侧壁处;所述容纳腔的一个开口处设有限位卡条,所述盖板上设有卡槽,且卡槽与限位卡条相配合;所述限位卡条包括延伸部和固定部,所述卡槽包括第一限位槽和第二限位槽,并分别与延伸部和固定部配合;综上,基于壳体与盖板相互配合,实现对锂电池池芯的封闭防护,有效避免锂电池出现爆炸问题,从而提高了锂电池的使用安全性;并且,本实用新型中,壳体与盖板配合方便,结构稳定、密封性好。

 883
883
 0
0
本申请提供一种锂离子电池非水电解液,包含非水有机溶剂和锂盐,还包含选自式1所示的化合物中的一种或多种化合物和式2所示的化合物,其中R1、R2、R3、R4各自独立地选自取代或未取代的1‑5个碳原子的烷基、醚基、不饱和烃基,R1、R2、R3、R4中的至少一个为所述取代或未取代的2‑5个碳原子的不饱和烃基,R5选自取代或未取代的1‑5个碳原子的亚烷基、醚基;R6、R7、R8各自独立地选自取代或未取代的1‑5个碳原子的烷基、醚基、不饱和烃基,但条件是R6、R7、R8中的至少一个为所述取代或未取代的2‑5个碳原子的不饱和烃基。本发明还提供包含该非水电解液的锂离子电池。本发明的非水电解液能够兼顾电池高温储存性能及循环性能。

 1158
1158
 0
0
本发明通过将天然石墨和人造石墨按照特定比例混合后作为锂离子电池的负极材料,天然石墨在两者中所占体积比为61%~69%,能够很好地减少负极材料低温析锂现象,改善锂离子电池的低温性能。本发明的方法简单,易于工业推广应用。

 893
893
 0
0
本发明提供了一种碳包覆磷酸铁锂正极材料、其制备方法及锂离子电池。该碳包覆磷酸铁锂正极材料的制备方法包括:在第一惰性气氛下,使锂源和亚铁源及第一溶剂进行第一次混合,得到第一原料液;在第二惰性气氛下,使磷源、辅助剂及第二溶剂进行第二次混合,得到第二原料液,辅助剂选自龙胆二糖和/或龙胆三糖;使第一原料液和第二原料液进行水热合成反应,得到含碳非晶包覆层的磷酸铁锂;及在第三惰性气氛下,使含碳非晶包覆层的磷酸铁锂进行烧结,得到碳包覆磷酸铁锂正极材料。采用上述方法能够大大提高正极材料中碳包覆层均匀性,从而能够大幅提高其导电性能及能量密度。

 1001
1001
 0
0
本申请属于锂离子电池技术领域,涉及一种电池电解液用添加剂、锂离子电池电解液、锂离子电池。本申请提供了一种电池电解液用添加剂,至少包括如下结构式Ⅰ和式Ⅱ所示化合物中的至少一种,

 892
892
 0
0
本发明公开了一种锂离子电池磷酸铁锂正极材料的回收再生方法,其包括如下步骤:获取来自废旧锂离子电池中的含有磷酸铁锂的正极,采用清洗剂超声处理正极,使得正极材料与集流体分离,清洗剂包括能够溶解掉正极中粘结剂的有机溶剂;分析正极材料中的各元素比例,并向正极材料中补充锂元素和/或磷元素至其中锂元素、磷元素和铁元素的物质的量的比例为(1~1.1):(1~1.1):1,制备前驱体;将前驱体与有机物碳源混合,于保护性气氛下煅烧使得有机物碳源碳化,制备再生正极活性材料。该方法实现了对废旧电池中的固体磷酸铁锂正极材料的直接回收及再生。

 843
843
 0
0
本发明提供了一种磷酸铁锂、其制备方法、锂离子电池及电力驱动装置。该方法包括:在第一惰性气氛和酸性条件下,使可溶性锂源化合物、可溶性二价铁源化合物和可溶性磷源化合物与水进行第一水热合成反应,得到第一固液混合物;对第一固液混合物进行强制分散,得到分散液;在第二惰性气氛下,使分散液进行第二水热合成反应,得到磷酸铁锂,第二水热合成反应的温度高于第一水热合成反应的温度,在第二水热合成反应过程中进行原料补充。采用上述方法制得的磷酸铁锂材料具有杂相少,纯度高,粒度分布均匀,有利于缩短锂离子在材料中的扩散路径,从而能够大大提升材料的动力性能。作为锂离子电池正极材料,能够表现出优异的电化学性能。

 893
893
 0
0
本实用新型涉及电池技术领域,具体为一种锂离子电池的隔膜以及锂离子电池。该锂离子电池的隔膜包括隔膜、正极活性层膜和负极活性层膜,所述隔膜位于所述正极活性层膜与所述负极活性层膜之间。该锂离子电池的隔膜消除了隔膜与正负极之间的间隙,增加了隔膜的机械性、热稳定性,提高了锂离子电池的使用寿命和安全性能。

 702
702
 0
0
本发明公开了锂电池浸润工艺和锂电池浸润化成方法,其中,锂电池浸润工艺包括将极片卷芯安装于具有一端开口的外壳内部以制成半成品电池;在温度为T1的半成品电池中注入电解液,在半成品电池中注入电解液之后,将电池转移到手套箱内部的真空室内、进行抽真空,直至真空室内部的真空度达到P,保压时间为t,其中,T1=65℃±5℃,P=(‑0.075)MPa~(‑0.065)MPa,t=60s~80s;将完成注液浸润步骤之后的半成品电池进行封口以制成成品电池;将成品电池先倒立搁置浸润,再直立搁置浸润。本发明公开的锂电池浸润化成工艺具有提高了电解液的浸润效果,极片上不会出现析锂的现象,提高了产品的良品率的优点。

 969
969
 0
0
本发明提供一种氟磺酸锂的制备方法和氟磺酸锂及应用,其通过将三氧化硫与氟气反应生成双氟磺酰基过氧化物,然后将所述双氟磺酰基过氧化物加入于包含氢化锂的非水溶剂中,反应生成氟磺酸锂。在本方法中,通过精密地控制反应摩尔比和温度等工艺条件,成功地制备出收率和纯度高的氟磺酸锂。由于在反应过程中没有使用氯磺酸、氟磺酸等强酸性原料,副反应少,废气少,制备步骤相对简单,产品的纯度和收率高,有利于在制备锂电池的电解液的工业上生产应用。

 779
779
 0
0
本发明公开了一种锂电池极耳、锂电池及其制备方法,锂电池极耳,其特征在于,包括极耳本体和设置在极耳本体上的附着件,附着件环绕附着在极耳本体上,或附着件附着在极耳本体的其中一侧。该锂电池极耳、锂电池及其制备方法易于实施,形成的锂电池可靠性高,结构稳固,不易短路。

 1124
1124
 0
0
本发明涉及一种用于锂离子电池粉体材料深度干燥的微孔容器和深度干燥方法。本发明所述微孔容器的微孔孔径≤锂离子电池粉体材料的平均粒径,并耐300℃及以下的干燥温度,确保了在<100Pa的高真空度下基本不漏料,收料率接近100%;所述深度干燥方法是将粉体材料封装在微孔容器内,置于真空干燥设备里,通入循环热导干燥气体使物料升温并保温预热,再抽真空至预设的超高真空度,干燥,通入循环冷导干燥气体降温,再将之转移至与干燥设备串联的低露点值环境内,取出物料并封口储存。本发明所述深度干燥方法可获得常规干燥条件下难以达到的极低水分含量的锂离子电池电极材料,具有重要的应用价值。

 1121
1121
 0
0
本发明公开了一种从废旧三元锂电池回收贵金属镍钴锰锂的方法,包括酸浸、除杂、沉淀、分离、滤渣处理和滤出液处理;酸浸:将三元锂电池阳极材料破碎成粉末并溶于酸液中,之后,往酸液中加入还原剂使三元锂电池阳极材料中的金属与酸液反应,在此过程中,将酸液加热至95℃并进行搅拌,使可与酸液反应的金属完全溶解于酸液中,不与酸液反应的金属沉淀;之后,进行过滤,得到滤液A1和滤渣B1。本发明主要使用酸浸--逐步分离的方式提取废旧三元锂电池粉末中各种贵金属,使用物理--化学方法,利用各种金属物质各自特有的化学性质,从混合金属粉末中分离出各种金属物质,解决了传统处理方式的能耗大、投入成本高、运行过程不稳定的弊病。

 793
793
 0
0
本发明提供一种进一步提高锂离子电池的高温储存性能与循环性能的锂离子电池用非水电解液,以及应用该电解液的锂离子电池,所述锂离子电池用非水电解液含有:锂盐、有机溶剂以及环戊二烯类化合物;所述环戊二烯类化合物选自以下物质中的一种或多种:环戊二烯、环戊二烯多聚体、环戊二烯衍生物以及所述环戊二烯衍生物的多聚体,所述环戊二烯衍生物的结构如结构式1所示,其中R选自碳原子数为1-4的烷基。结构式1。

本发明提出了一种锂离子电池正极片制造方法,该方法包括正极活性材料浆料制备工序和浆料涂布工序,其中正极活性材料浆料制备工序包括以下步骤:将明胶水溶液与正极活性材料粉粒混合;在混合物中加入导电炭黑,使导电炭黑均匀地分布于正极活性粉粒表面上;再加入辅助粘接剂,形成膏状浆料,所述辅助粘接剂用于协同明胶提高粘接力和极片的柔软性,本发明还涉及用此方法制造的锂离子电池的正极片及使用该正极片的锂离子电池,使用本方法制造出的极片不仅其物理性能符合规模化生产要求,而由它制成的电池的电化学性能与现时普遍使用的油基涂布法制造出的电池的电化学性能十分一致,并且避免了油相涂布方法产生的有机物污染。

 1108
1108
 0
0
本申请涉及锂离子电池加工技术领域,具体公开了一种锂离子电池用隔膜及制备方法和锂离子电池,隔膜包括多孔性基材、有机改性聚合物蜡涂层、无机陶瓷涂层;有机改性聚合物蜡涂层的原料为改性聚合物蜡乳液,以干料计,改性聚合物蜡乳液包括以下原料制备而成:表面含有接枝改性极性官能团的改性聚合物蜡颗粒、水溶液型粘接剂、水溶液型高分子增稠剂;无机陶瓷涂层的原料为陶瓷浆料,以干料计,陶瓷浆料包括以下原料制备而成:陶瓷微粒、水溶型高分子增稠剂、水溶液型粘接剂、乳液型粘结剂。锂离子电池用隔膜不仅保持良好的锂离子电导率、浸润性,而且具有良好的热稳定性,使锂离子电池具有良好安全性、放电倍率性、长期循环稳定性的优点。

 1022
1022
 0
0
本发明属于锂硫电池技术领域,尤其涉及一种锂硫电池用隔膜,包括隔膜基体,还包括覆盖层,覆盖层包括石墨烯和异质结纳米材料,异质结纳米材料为共生的强吸附性相?强导电性相,石墨烯与异质结纳米材料的质量比为(3?15):1,异质结纳米材料中,强吸附性相与强导电性相的质量比为(1?10):(10?1)。相对于现有技术,本发明通过在隔膜上设置覆盖层,可以大大提升锂硫电池的电化学和动力学性能。具体而言,异质结纳米材料包括对多硫化物具有强吸附作用的强吸附性相和具有高导电性的强导电性相两相,强吸附性相吸附的多硫化物可以扩散到强导电性相表面完成转化,强吸附性相和强导电性相两相界面处也可完成吸附和转化,抑制多硫化物的“穿梭效应”。

 736
736
 0
0
本发明提供了一种锂离子电池复合电极片,由电极片和设置在电极片表面的隔膜层组成,电极片由集流体和涂覆在集流体表面的电极活性材料组成,隔膜层的材料包括无机陶瓷颗粒,粘结剂以及有机纤维,有机纤维的熔点大于200℃,有机纤维的直径为0.1μm~10μm,长度为1mm~10mm,有机纤维的质量为无机陶瓷颗粒质量的0.1%~2%。该锂离子电池复合电极片,隔膜层在电极片上附料稳固,并且热稳定性好,可解决现有技术中隔膜层在卷绕的过程中易产生裂纹以及掉料的问题,能够提高锂离子电池的安全性能和循环使用寿命。本发明实施例还提供了该锂离子电池复合电极片的制备方法、以及包含该锂离子电池复合电极片的锂离子电池。

 833
833
 0
0
本实用新型涉及一种移动基站用低温型锂离子电池极片及锂离子电池。该移动基站用低温型锂离子电池极片包括集流体和设于集流体至少一侧的活性物质层,还包括位于活性物质层的远离集流体一侧的功能层,用于在电池温度高时吸热、外界温度低时放热。本实用新型提供的移动基站用低温型锂离子电池极片,功能层设置于活性物质层外侧,在制作电池时功能层与隔膜直接接触,而该部位是电池中电阻最大的部位,在电池工作过程中,功能层可最大程度吸收热量、储存能量,在锂离子电池处于低温条件时,可将能量释放出来,激活锂离子的传输速率并促进电化学反应的进行,从而提高锂离子电池的低温电化学性能。

 1116
1116
 0
0
本发明公开了一种高安全的锂离子电池正极极片及包含该正极极片的锂离子电池,正极极片包括正极集流体和附设在正极集流体阴阳面的正极活性材料层,正极集流体表面涂覆有无机聚硅氮烷‑聚多巴胺‑石墨烯复合涂层,正极活性材料材料层涂覆在无机聚硅氮烷‑聚多巴胺‑石墨烯复合涂层表面。本发明的高安全的锂离子电池正极极片具有有效避免析铜现象、避免热累积、倍率性能优异和循环寿命好的特点。
北方有色为您提供最新的广东深圳有色金属加工技术理论与应用信息,涵盖发明专利、权利要求、说明书、技术领域、背景技术、实用新型内容及具体实施方式等有色技术内容。打造最具专业性的有色金属技术理论与应用平台!
 2026年03月20日 ~ 22日
2026年03月20日 ~ 22日  2026年03月20日 ~ 22日
2026年03月20日 ~ 22日  2026年03月25日 ~ 27日
2026年03月25日 ~ 27日  2026年03月26日 ~ 28日
2026年03月26日 ~ 28日  2026年03月27日 ~ 29日
2026年03月27日 ~ 29日 
